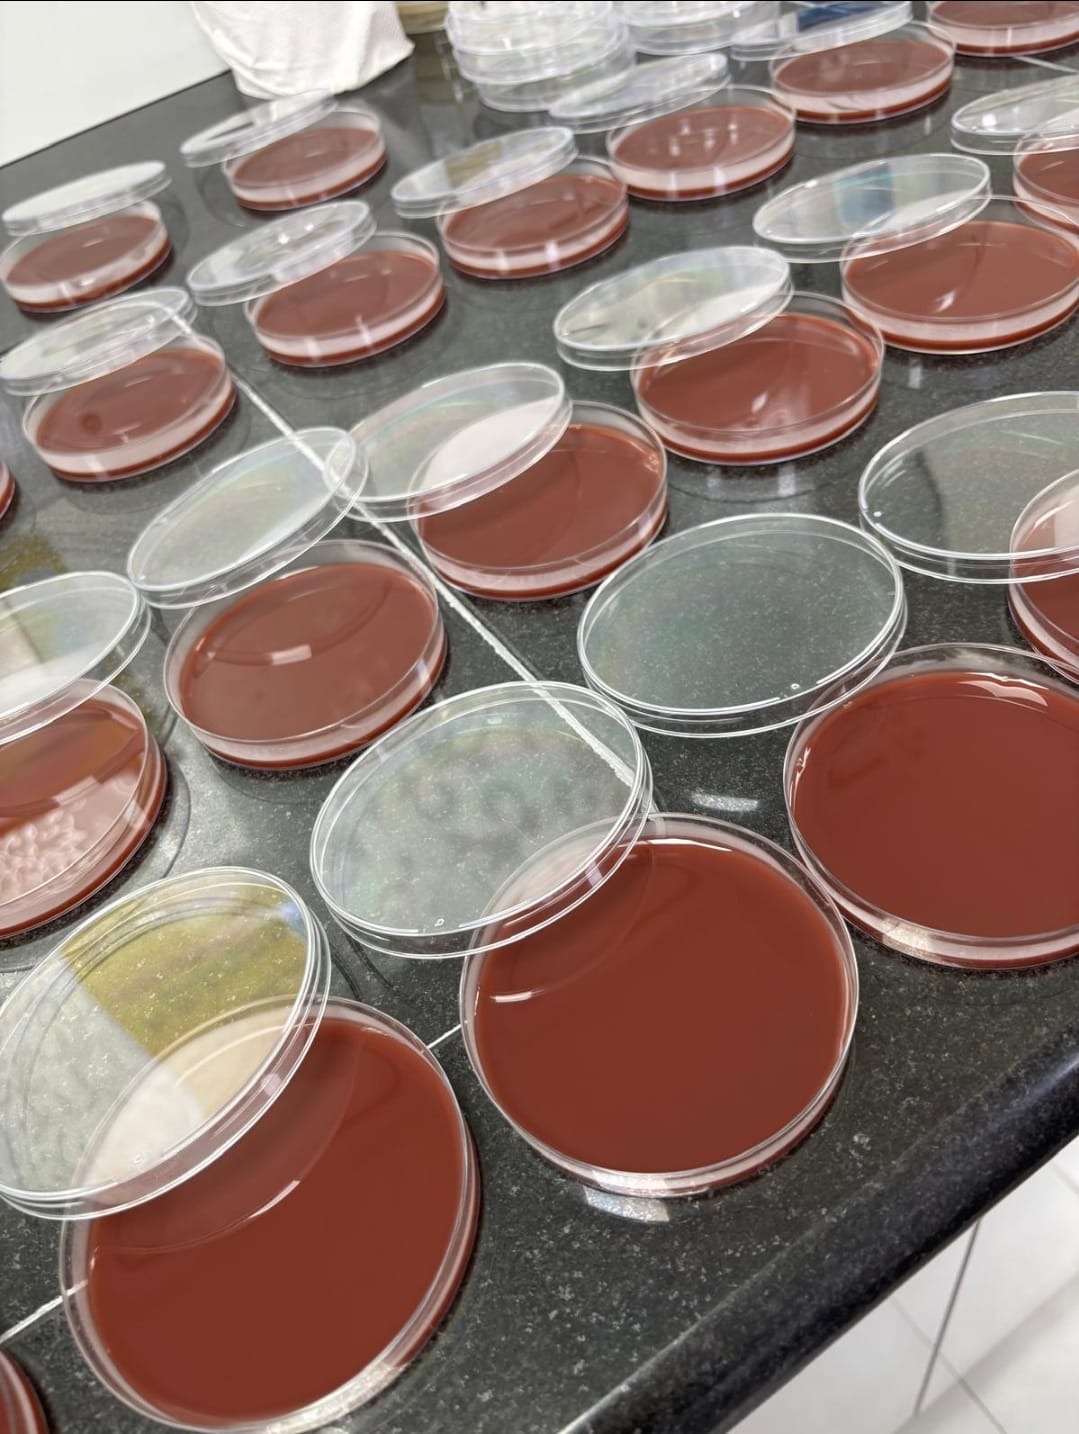

تدريب طلبة من الأحياء التطبيقية في مختبرات الأحياء الدقيقة بالمستشفى الأهلي
بدأ عدد من طلبة قسم الأحياء التطبيقية بكلية العلوم التطبيقية برنامجًا تدريبيًا مكثفًا في مختبرات الأحياء الدقيقة بالمستشفى الأهلي، وذلك ضمن متطلبات مساق الأحياء الدقيقة الطبية، وبإشراف الأستاذة أروى مجاهد.

ويهدف البرنامج إلى إكساب الطلبة المهارات العملية اللازمة للتعامل مع العينات المخبرية، والتعرف على طرق العزل والزراعة والتشخيص الجرثومي، بالإضافة إلى تدريبهم على استخدام الأجهزة المخبرية الحديثة واتباع معايير السلامة الحيوية داخل المختبر.

وأشادت الأستاذة أروى مجاهد بحماس الطلبة والتزامهم، مؤكدة أن التدريب العملي يمثل خطوة جوهرية في تعزيز فهمهم للتطبيقات الطبية في تخصص الأحياء الدقيقة، ويهيئهم لسوق العمل من خلال صقل مهاراتهم المخبرية.
كما تتقدم كلية العلوم التطبيقية بالشكر والتقدير لكل من أسهم في تسهيل تنفيذ هذا التدريب، من إدارة الكلية، وإدارة المستشفى الأهلي، وإدارة المختبر ممثلة بالدكتور عيسى دعنا، على تعاونهم ودعمهم في توفير بيئة تدريبية ملائمة تساهم في تعزيز خبرات الطلبة وتنمية قدراتهم العلمية والعملية.
ويأتي هذا التعاون في إطار حرص كلية العلوم التطبيقية على توفير بيئة تعليمية متكاملة تجمع بين الجانب النظري والتطبيقي، بما يضمن إعداد كوادر مؤهلة لتكون متميزة في سوق العمل.